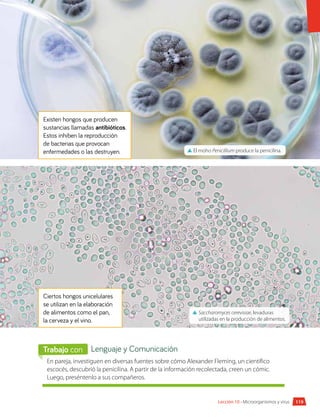
119
Lección 10 • Microorganismos y virus
Existen hongos que producen
sustancias llamadas antibióticos.
Estos inhiben la reproducción
de bacterias que provocan
enfermedades o las destruyen.
Ciertos hongos unicelulares
se utilizan en la elaboración
de alimentos como el pan,
la cerveza y el vino.
▲
▲ El moho Penicillium produce la penicilina.
▲
▲ Saccharomyces cerevisiae, levaduras
utilizadas en la producción de alimentos.
En pareja, investiguen en diversas fuentes sobre cómo Alexander Fleming, un científico
escocés, descubrió la penicilina. A partir de la información recolectada, creen un cómic.
Luego, preséntenlo a sus compañeros.
Lenguaje y Comunicación
Trabajo con

1. En la imagen se puede desarrollar vida en los océanos y lagos, ya que estos cuerpos de agua contienen agua líquida, que es un requisito fundamental para el desarrollo de los seres vivos.
2. La afirmación de que "sin agua no hay vida" es correcta porque el agua es esencial para todos los seres vivos. El agua participa en casi todas las reacciones químicas que ocurren en los seres vivos, como la fotosíntesis, la respiración celular y la digestión. Además, el ag